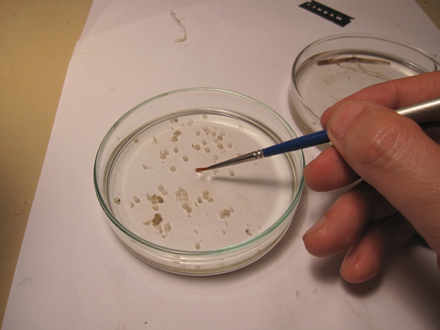

ニオイイリスの根の観察 |
| |
| はじめに |
| アヤメにはたくさんの種類があります。5~6月頃,各地のあやめ園を訪ねてみましょう。カキツバタ(Iris laevigata),ハナショウブ,イチハツ(I. tectorum),シャガ(I. japonica),ドイツアヤメ(ジャーマンアイリス)(I. germanica),ニオイイリス(I. germanica 'Florentina')など,様々なアヤメの仲間を見ることが出来るでしょう。ニオイイリスは名前の通り花が咲くと良く香ります。アヤメの仲間の根の内皮は細胞壁が肥厚するため,はっきりと内皮を観察することが出来ます。中でもニオイイリスとドイツアヤメの根の横断面は典型的な放射中心柱,放射維管束を観察することが出来ます。 |
| |
| |
 |
|
 |
|
| |
| 植物の根で見られる組織は,基本的に茎と一緒ですが,維管束の配置が異なっています。また,葉と茎では分からなかった内皮 endodermis がはっきりと観察出来ます。内皮が根でしか観察出来ないのは,内皮には根毛から吸収された水や無機物を選択的に維管束に送る役割があるからです。例えば,光合成を阻害するような薬品を根に与えても光合成にはほとんど影響がありません。これは内皮によって根から吸い上げる物質が制御されているからです。内皮の内側の維管束組織は,中心部に木部 xylemがあり,師部 phloemは木部の間に交互に配列しています。これを放射維管束 actinostele又は放射中心柱といいます。全ての維管束植物の根は放射維管束です。 |
| |
| 切片作製手順 |
| |
| |
 |
|
 |
|
| 根の切片作製は,茎と基本的に一緒です。掘り上げた根を良く水で洗い,ハサミで2, 3 cm位の長さに切ります。茎と同様に,カミソリで水平に切ります。 |
| |
| |
 |
|
|
|
| 作った切片は,カミソリ刃ごと水を入れたシャーレの中に入れます。たくさんの切片の中から,もっとも薄い切片を選び出し,面相筆で拾い上げます。 |
| |
|
|
| |
 |
|
 |
|
| 切片をスライドガラスに乗せ,カバーガラスをかけます。 |
| |
| 顕微鏡で観察する |
| 4倍または10倍の対物レンズで良く切れた切片を探します。10倍の対物レンズで放射中心柱を確認したら,40倍の対物レンズで観察し,根毛,内皮,師部の配置を観察します。 |
| |
| |
 |
|
 |
|
| |
根の横断面全体 |
|
根毛 root hair |
|
| |
| |
 |
|
 |
|
| |
放射中心柱 actinostele |
|
内皮 endodermisと放射維管束 actinostele |
|
| |
 |
| 根の横断面のスケッチ:師部を黄色,木部を赤で示した。木部の間に師部が配列する放射維管束である。内皮には細胞壁の肥厚が見られる。 |
| |




